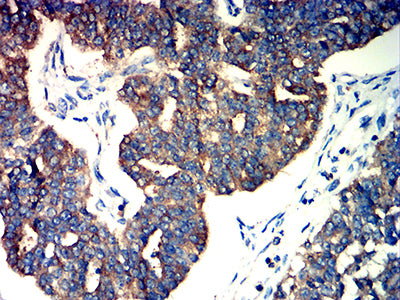
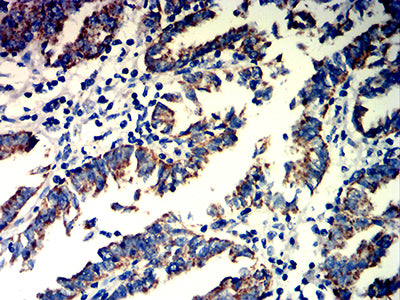

-
分类: 科研抗体货号: 32213别名:应用: FCM反应种属: Human
-
分类: 科研抗体货号: 32214别名: SIRPB1; SIRP-BETA-1应用: IHC,IF,FCM反应种属: Human
-
分类: 科研抗体货号: 32228别名: CLEC2; CLEC2B; PRO1384; QDED721; 1810061I13Rik应用: IHC,FCM反应种属: Human
-
分类: 科研抗体货号: 32212别名: SMPR; MPR46; CD-MPR; MPR 46; MPR-46; CD-M6PR应用: WB,IHC,FCM反应种属: Human, Mouse
-
分类: 科研抗体货号: 32227别名: RY; APG-2; HSPH2; HSPA4 ; hsp70RY; HEL-S-5a; HS24/P52应用: WB,IHC,FCM反应种属: Human, Mouse, Rat, Monkey
-
分类: 科研抗体货号: 32211别名: SMPR; MPR46; CD-MPR; MPR 46; MPR-46; CD-M6PR应用: WB,IHC,FCM反应种属: Human, Mouse
-
分类: 科研抗体货号: 32226别名: RCC; SCAR26应用: WB,IHC,FCM反应种属: Human, Monkey
-
分类: 科研抗体货号: 32210别名: CXCR6; BONZO; CDw186; STRL33; TYMSTR应用: FCM反应种属: Human
-
分类: 科研抗体货号: 32225别名:应用: WB,IHC,FCM反应种属: Human
-
分类: 科研抗体货号: 32208别名: FMLPY; FPRH1; FPRH2; FPRL2; RMLP-R-I; FMLP-R-II; FML2_HUMAN应用: IHC,FCM反应种属: Human

鄂公网安备42018502007531号
鄂公网安备42018502007531号

